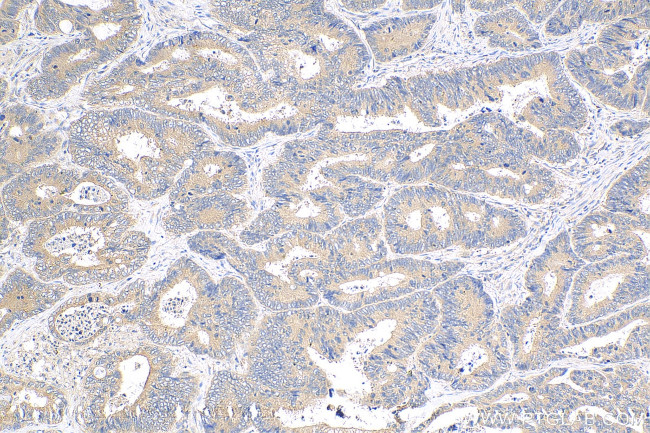
CCM3/PDCD10 Antibody in Immunohistochemistry (Paraffin) (IHC (P))

Search
Proteintech
CCM3/PDCD10 Polyclonal Antibody
{{$productOrderCtrl.translations['antibody.pdp.commerceCard.promotion.promotions']}}
{{$productOrderCtrl.translations['antibody.pdp.commerceCard.promotion.viewpromo']}}
{{$productOrderCtrl.translations['antibody.pdp.commerceCard.promotion.promocode']}}: {{promo.promoCode}} {{promo.promoTitle}} {{promo.promoDescription}}. {{$productOrderCtrl.translations['antibody.pdp.commerceCard.promotion.learnmore']}}
产品信息
10294-2-AP
种属反应
已发表种属
宿主/亚型
分类
类型
抗原
偶联物
形式
浓度
规格
纯化类型
保存液
内含物
保存条件
运输条件
产品详细信息
10294-2-AP is a rabbit polyclonal antibody raised against the full-length PDCD10 of human origin.
Immunogen sequence: KNEAETTSM VSMPLYAVMY PVFNELERVN LSAAQTLRAA FIKAEKENPG LTQDIIMKIL EKKSVEVNFT ESLLRMAADD VEEYMIERPE PEFQ (9-101 aa encoded by BC002506)
靶标信息
This gene encodes an evolutionarily conserved protein associated with cell apoptosis. The protein interacts with the serine/threonine protein kinase MST4 to modulate the extracellular signal-regulated kinase (ERK) pathway. It also interacts with and is phosphoryated by serine/threonine kinase 25, and is thought to function in a signaling pathway essential for vascular developent. Mutations in this gene are one cause of cerebral cavernous malformations, which are vascular malformations that cause seizures and cerebral hemorrhages. Multiple alternatively spliced variants, encoding the same protein, have been identified.
仅用于科研。不用于诊断过程。未经明确授权不得转售。
生物信息学
蛋白别名: apoptosis-related protein; apoptosis-related protein 15; Cerebral cavernous malformations 3 protein; MGC1212; MGC24477; PDCD 10; PDCD10; Programmed cell death protein 10; TF-1 cell apoptosis-related protein 15; unnamed protein product
基因别名: 2410003B13Rik; CCM3; PDCD10; Tfa15; TFAR15
UniProt ID: (Human) Q9BUL8, (Rat) Q6NX65, (Mouse) Q8VE70
Entrez Gene ID: (Human) 11235, (Rat) 494345, (Mouse) 56426